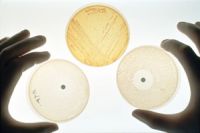

La Banque centrale européenne (BCE) a franchi jeudi l’étape ultime en matière de politique monétaire en lançant un programme de rachats d’obligations d’Etat qui lui permettra d’injecter des centaines de milliards d’euros dans le système financier de la zone euro pour tenter de relancer le crédit et l’activité.
La Banque centrale européenne (BCE) a franchi jeudi l’étape ultime en matière de politique monétaire en lançant un programme de rachats d’obligations d’Etat qui lui permettra d’injecter des centaines de milliards d’euros dans le système financier de la zone euro pour tenter de relancer le crédit et l’activité.
VIVE LA RÉVOLUTION
Celui qui dit la vérité, il doit être exécuté !
Derniers articles
-
BCE - 22 janvier 2015 - La Banque Centrale Européenne se décide enfin à faire tourner la planche à billets !
22 janvier 2015, par anonyme -
Mystérieux « suicide » du policier chargé de la connexion Charlie Hebdo-Jeannette Bougrab
22 janvier 2015, par anonyme Le témoignage troublant de la famille d’Helric Fredou, commissaire de police chargé de rédiger un rapport sur l’entourage familial de Charlie Hebdo et retrouvé mort d’une balle dans la tête quelques heures après l’attentat.
Le témoignage troublant de la famille d’Helric Fredou, commissaire de police chargé de rédiger un rapport sur l’entourage familial de Charlie Hebdo et retrouvé mort d’une balle dans la tête quelques heures après l’attentat.Mon frère avait lui-même trouvé deux suicidés — dont l’un à Melun — et avait dit à maman « je te ferai jamais un truc comme ça », à savoir me tuer et te laisser seule. Il n’était pas dépressif"
La "famille de victime" domiciliée aux environs de "Châteauroux" — selon les journalistes de Limoges — n’est jamais explicitement identifiée dans les rares articles faisant état de la mort d’Helric Fredou.
Curieuse omission : un simple recoupement, basé sur la consultation de la presse locale, permet de déduire qu’il s’agit des parents de Jeannette Bougrab, militante UMP qui affirme aujourd’hui avoir été la compagne du directeur assassiné de Charlie Hebdo.
-
Les Amerloques lancent un programme pour former 5000 djihadistes par an en Syrie
21 janvier 2015, par anonyme
Le Pentagone va déployer plus de 400 formateurs militaires et des centaines de personnels supplémentaires sur quatre sites d’entraînement répartis dans trois pays, début mars, dans le cadre d’un plan d’aide aux rebelles syriens.
-
Dictature sioniste française - 21 janvier 2015 - Deux ans de prisons pour quelques mots !
21 janvier 2015, par anonymeOn me demandait il y a quelques jours si je pensais à ce qui m’arriverait si les Islamistes arrivaient au pouvoir en France. Je n’y pense pas : ça me parait de la politique-fiction. Par contre je vois très bien ce qui m’arriverait si j’osais exprimer une opinion hérétique sur le terrorisme.
-
Palestine - 21 janvier 2015 - Israël voudrait dissoudre la Cour pénale internationale de La Haye (CPI)
21 janvier 2015, par anonyme
Le ministre israélien des Affaires étrangères Avigdor Lieberman a annoncé qu’avec l’aide de ses alliés, son pays chercherait à faire dissoudre la Cour pénale internationale de La Haye (CPI), écrit mardi le quotidien Novye Izvestia.
Les Israéliens sont indignés par la décision de cette dernière d’entamer une "analyse préliminaire de la situation en Palestine". Cette analyse pourrait déboucher sur des accusations de crimes de guerre envers les dirigeants israéliens.
La Cour pénale internationale a promis l’ouverture d’une enquête sur les agissements israéliens dans les territoires occupés.
Voici un indispensable document sur la torture des enfants palestiniens par Israël.
-
Qui commande en France ?
21 janvier 2015, par anonymeSelon l’Obs de cette semaine, la marche républicaine devait, dans un premier temps, se dérouler le samedi 10 janvier 2015. Mais, "l’Agité qui a changé" a fait remarquer à "François le Mol" que le samedi, c’est Shabbat !
-
France - Coup d’État du 7 janvier 2015 - La dictature sioniste supprime la liberté d’expression
20 janvier 2015, par anonyme
Depuis son coup d’État du 7 janvier 2015, la dictature sioniste se croit suffisamment puissante pour supprimer la liberté d’expression tout en prétendant la défendre. Nous sommes en plein 1984 : le mensonge, c’est la vérité ; la guerre, c’est la paix, l’interdiction de parler, c’est la liberté d’expression. Voici quelques exemples :
A Orléans (Loiret), un jeune homme de 20 ans qui avait crié « Vive la kalach » en direction de policiers, et qui avait présenté des excuses au tribunal pour sa bravade, se prend 6 mois ferme.
A Chartres (Eure-et-Loire), un homme de 21 ans, qui avait écrit sur sa page Facebook « Un coup de crayon et un coup de kalach c’est la même chose », se prend 12 mois ferme.
A Nice (Alpes-Maritimes), ce sont 10 mois ferme pour un homme de 22 ans, en état d’ébriété, qui aurait apostrophé les policiers en ces termes : « On va tous vous niquer à la kalach »
A Toulouse (Haute-Garonne), 10 mois ferme pour un homme de 21 ans sans titre de transport dans le métro qui aurait déclaré : « Les frères Kouachi, c’est que le début, j’aurais dû être avec eux ».
Et c’est 1 an ferme à Reims (Marne), pour des provocations analogues, proférées par un homme de 21 ans, sans emploi. Et puis, à Bourgoin-Jallieu (Isère), 6 mois ferme pour un homme reconnu déficient mental qui avait dit –toujours à des policiers- « Ils ont tué Charlie, moi j’ai bien rigolé ».
À Nice, le seul reproche qui est fait à un adolescent de 17 ans est d’avoir crié « Allah Akbar » !
ETC.
-
Exposition sur le nazisme censurée en France à la demande de la Lettonie (vidéo)
20 janvier 2015, par anonymeMoscou invite les organisations internationales à condamner la glorification du nazisme en Lettonie.
L’exposition consacrée aux prisonniers du camp de concentration de Salaspils en Lettonie, qui devait s’ouvrir dans une semaine à Paris, a été annulée, rapportent des représentants de la fondation Mémoire historique. La radio Govorit Moskva précise que cette décision a été prise par l’ambassade de Lettonie après des consultations avec le ministère des Affaires étrangères.
-
DONBASS 2015 Nouvelle Solidarité
20 janvier 2015 Le conflit ukrainien a été un des évènements majeurs de 2014, et parmi les trop nombreux conflits nouveaux, celui qui a pris la plus grande importance stratégique, en termes de remise en cause des équilibres géostratégiques, en termes de risques de guerre à grande échelle.
Le conflit ukrainien a été un des évènements majeurs de 2014, et parmi les trop nombreux conflits nouveaux, celui qui a pris la plus grande importance stratégique, en termes de remise en cause des équilibres géostratégiques, en termes de risques de guerre à grande échelle.Avec les évènements récents en France et leurs conséquences nationales et internationales, on comprend mieux qu’il s’inscrivait déjà dans une stratégie globale de l’impérialisme US pour tenter de compenser la crise qu’il a lui-même engendré par sa putréfaction financière.
Semer le chaos et la terreur en utilisant tous les moyens de diviser les peuples, et tout d’abord le communautarisme ethnique et religieux, et se présenter ensuite en "sauveur" en imposant leur domination économique et idéologique au mépris du droit des peuples à disposer d’eux-mêmes, voilà ce qu’ils ont tenté là comme ailleurs…
-
Marx a dit qu’il n’y avait pas de méchants coupables !
19 janvier 2015Capitalisme, exploitation de l’homme par l’homme : si Marx a dit qu’il n’y avait pas de méchants coupables, c’est parce qu’il est né dans la grande bourgeoisie. Il ne voulait pas qu’en cas de révolution sa famille soit décapitée. Cela a troublé son raisonnement.
-
La culture algérienne ne peut se passer des gymnases de l’art.
18 janvier 2015, par anonymeLa place de l’éducation artistique dans l’enseignement secondaire en Algérie. Comprendre les enjeux culturels et comportementaux dans les pays anciennement colonisés.
-
La marche accélérée du désarmement culturel de l’Algérie
18 janvier 2015, par anonymeLe désarmement culturel de notre pays vient de connaître un nouveau développement encore plus dangereux que les tendances lourdes à l’abandon national relevées ces dix dernières années. Le très visible financement par l’Algérie de deux films inventant à l’ALN des origines puis des aboutissements maffieux cache des réalités bien plus graves.
Les affaires du boycott du Salon du livre de Paris de 2008 consacré à la naissance d’Israël, puis de la caravane censée nous professer la bonne lecture de Camus, ont révélé la présence tentaculaire et la puissance d’un lobby néo-colonial qui s’est ouvertement attaqué à la légitimité du 1er novembre.
-
La communauté hassidique de l’extrême à ultra extrême.
17 janvier 2015, par anonymeLa communauté hassidique de l’extrême à ultra extrême. Le culte des Juifs est bizarre et lugubre » (Tacite dans les « Histoires », livre 5,5). On les reconnaît à leurs vêtements, souvent un peu trop sobres pour de si jeunes femmes, et à ces cheveux synthétiques qui camouflent discrètement leurs boucles lustrées. Il y a aussi le groupe d’enfants à leurs trousses ; des enfants par dizaines,. Même si elles sont moins stigmatisées que les hommes de leur religion, leur bonheur spirituel leur permettant de (...) -
Hécatombe
17 janvier 2015, par anonymeUn grand classique de Georges Brassens -
Charlie Hebdo - Comme d’habitude Jean-Marie Le Pen vient au secours du pouvoir
17 janvier 2015, par doC’est habituel, chaque fois que le pouvoir ne veut pas qu’une vérité se propage dans la population, il la fait dire par le Pen. Comme ça, chaque fois que quelqu’un dira cette vérité, les propagandistes du pouvoir pourront répondre : « Ha bon ! vous êtes d’accord avec Le Pen ! »
J’ai remarqué cela à l’époque du SIDA, quand la thèse de l’invention du rétrovirus du SIDA dans les laboratoires américains a commencé à se faire jour grâce au professeur Segal de RDA, qui avait publié un excellent article dans les Nouvelles de Moscou. "On" a fait dire à Le Pen que le SIDA avait été fabriqué dans des labos américains afin que cette thèse puisse être présentée comme une thèse fasciste.
J’ai remarqué ce phénomène plusieurs autres fois qui ne me reviennent pas à l’esprit. Et là, au moment où le pouvoir n’arrive pas à se dépêtrer de ce qu’il nomme "théorie du complot" au sujet des attentats chez Charlie Hebdo et à l’Hyper cacher, Le Pen vient dire qu’il est bien d’accord avec cette "théorie du complot". Maintenant, "on" va pouvoir dire que c’est une "théorie fasciste" !
Mais me direz-vous, pourquoi Le Pen viendrait-il ainsi au service du pouvoir chaque fois que celui-ci en a un urgent besoin. Simple, il a torturé en Algérie au service de l’impérialisme français. Il n’est jamais passé en procès pour ça, malgré la gigantesque campagne du Canard Enchainé pendant 6 mois en 1984. Campagne où le Canard présentait chaque semaine des témoignages d’Algériens torturés par le Pen, certains étant même des personnes assez haut placées, des maires, etc. Le but du Canard était d’empêcher le Pen d’avoir le droit de se présenter aux Européennes de l’époque, en partant du principe que la torture est un crime contre l’humanité et que c’est donc imprescriptible. Cette campagne n’a été reprise par aucun autre journal. Et le Pen a pu se présenter. L’État n’a rien fait contre ça. Et le Pen contre Chirac en 2002, quelle aubaine pour la droite ! Le Pen, j’en suis bien sûr appartient toujours à l’armée et est toujours prêt à rendre service à l’État. Ne vous étonnez pas si les médias du pouvoir préfèrent faire de la pub à le Pen plutôt qu’à Besancenot ou Krivine, Shivardi ou Gluckstein, Arthaud ou Laguiller !
-
Schlomo Sand : « Je ne suis pas Charlie »
17 janvier 2015, par anonyme On fait valoir que Charlie s’en prend, indistinctement, à toutes les religions, mais c’est un mensonge. Certes, il s’est moqué des chrétiens, et, parfois, des juifs ; toutefois, ni le journal danois, ni Charlie ne se seraient permis, et c’est heureux, de publier une caricature présentant le prophète Moïse, avec une kippa et des franges rituelles, sous la forme d’un usurier à l’air roublard, installé au coin d’une rue.
On fait valoir que Charlie s’en prend, indistinctement, à toutes les religions, mais c’est un mensonge. Certes, il s’est moqué des chrétiens, et, parfois, des juifs ; toutefois, ni le journal danois, ni Charlie ne se seraient permis, et c’est heureux, de publier une caricature présentant le prophète Moïse, avec une kippa et des franges rituelles, sous la forme d’un usurier à l’air roublard, installé au coin d’une rue.En 1886, fut publiée à Paris La France juive d’Edouard Drumont, et en 2014, le jour des attentats commis par les trois idiots criminels, est parue, sous le titre : Soumission, « La France musulmane » de Michel Houellebecq. La France juive fut un véritable « bestseller » de la fin du 19e siècle ; avant même sa parution en librairie, Soumission était déjà un bestseller ! Ces deux livres, chacun en son temps, ont bénéficié d’une large et chaleureuse réception journalistique. Quelle différence y a t’il entre eux ? Houellebecq sait qu’au début du 21e siècle, il est interdit d’agiter une menace juive, mais qu’il est bien admis de vendre des livres faisant état de la menace musulmane.
-
Charlie Hebdo - UJFP - L’union Juive Française pour la Paix dit non à la guerre !
17 janvier 2015, par anonyme Nous vivons une affaire Dreyfus à l’envers. Il faut se démarquer, il faut un NON de résistance. Parce que suivre le processus engagé nous mène au gouffre. L’affaire Dreyfus portait la haute valeur du combat contre l’injustice et en cela était prometteuse de progrès. Aujourd’hui, c’est à la guerre qu’est mené notre peuple et l’avenir est prometteur de désastres, comme la guerre mondiale que refusait Jaurès.
Nous vivons une affaire Dreyfus à l’envers. Il faut se démarquer, il faut un NON de résistance. Parce que suivre le processus engagé nous mène au gouffre. L’affaire Dreyfus portait la haute valeur du combat contre l’injustice et en cela était prometteuse de progrès. Aujourd’hui, c’est à la guerre qu’est mené notre peuple et l’avenir est prometteur de désastres, comme la guerre mondiale que refusait Jaurès. -
Charlie Hebdo - Après la télé anglaise, la presse belge parle aussi de manipulation du terrorisme par l’État
17 janvier 2015, par anonymeLes enquêteurs ont retrouvé la carte d’identité de l’aîné des frères Kouachi dans la voiture abandonnée dans le nord-est de Paris. Comment des tueurs, commettant un attentat avec un sang-froid et une maîtrise qualifiés de professionnels, peuvent-ils commettre une telle erreur ? Ne pas s’encombrer de ses papiers fait pourtant partie de l’abc du simple cambrioleur.
Dans la version officielle du 11 septembre, le FBI affirmait avoir retrouvé le passeport intact de l’un des kamikazes, Satam Al Suqami, à proximité d’une des deux tours complètement pulvérisées par les explosions dégageant une température capable de faire fondre l’acier des structures métalliques d’un building, mais laissant intact un document en papier.
Depuis le 11/9, l’invraisemblable fait partie de notre quotidienneté. Il est devenu le fondement de la vérité. La Raison est bannie. Il ne s’agit pas de croire ce qui est dit, mais bien la voix qui parle, quel que soit le non-sens de l’énonciation. Plus celui-ci est patent, plus la foi en ce qui est affirmé devient indéfectible. L’invraisemblable devient ainsi la mesure et la garantie du vrai.
-
Charlie - Quand Siné dénonçait Charlie hebdo (vidéo 4’09)
16 janvier 2015, par anonyme« Ils bouffaient tous avec le pouvoir »
Cliquer sur l’image pour voir la vidéo.
NE VOUS ABONNEZ SURTOUT PAS À CHARLIE HEBDO !
ABONNEZ-VOUS PLUTÔT À SINÉ MENSUEL !
-
Charlie Hebdo - Le bluff terroriste ne prend pas, le pouvoir a loupé son coup !
16 janvier 2015, par anonyme
A Trappes, même les collégiens évoquent la théorie du complot et la liberté d’expression à deux vitesses.
« Vous ne trouvez pas ça bizarre, vous, tout ce qui s’est passé ? » A peine sortie du lycée pour la pause de midi, Amina, 16 ans, recoiffe le voile qu’elle avait dû ôter pour suivre les cours dans l’enceinte scolaire. Abritée sous un arbre avec deux copines alors que le vent souffle en tempête jeudi sur cette cité de banlieue, l’adolescente est aussi volubile que la pluie tombe à verse. « La théorie du complot ? Evidemment, on ne parle que de ça dans l’école ! » dit-elle. « Mais on évite de le faire devant les profs, des fois qu’ils feraient une fiche de renseignements sur nous. »
-
Terrorisme - 15 janvier 2015 à 19h36 - Toujours plus forts, les Belges !
15 janvier 2015, par doSTRATÉGIE DE LA TENSION Toujours plus forts, les Belges ! ils font carrément une opération "antiterroriste" sans même qu’il y ait eu d’opération terroriste préalable ! C’est du moins comme ça qu’à l’instant-même France 3 nous présente cet événement.
Il est intéressant de constater qu’au moment où l’affaire des "terroristes" de Charlie Hebdo commence à retomber, on retrouve le corps d’Hervé Gourdel en Algérie.
Comme tout le monde s’en est foutu, du corps d’Hervé Gourdel, et que ça n’a pas fait remonter la tension, il y a cette opération "antiterroriste" en Belgique ! Soit-disant une perquisition qui aurait mal tourné.
En fait, tout ça n’est que du spectacle, comme aurait dit Guy Debord. De même que les 10 000 soldats qui sont en train d’être déployés partout en France. Car ces soldats sont là pour être vus. Rien de plus. Ils seraient bien incapable d’empêcher les services secrets français de recommencer un coup comme à Charlie Hebdo ; ni même d’empêcher un quelconque attentat-suicide mené par un vrai islamiste, puisque c’est comme ça que procèdent les terroristes islamistes, qui, eux, loin de préparer leur fuite avec deux bagnoles, se préparent au contraire à mourir au milieu de leurs victimes.
-
Charlie - La démonstration de la manipulation du terrorisme devient implacable
15 janvier 2015, par doLa vérité est ailleurs qu’à la télévision ?
La démonstration qu’à Charlie Hebdo l’attentat terroriste a été organisé par l’État lui-même est devenue implacable depuis que j’ai actualisé, avec des éléments nouveaux, cet article qui dénonce comme un faux la vidéo où l’on voit le policier "mourir".
-
Charlie Hebdo - C’est même pas les frères Kouachi qui ont fait le coup ! (vidéo 24’’)
15 janvier 2015, par anonymeLes frères Kouachi n’avaient pas les yeux Bleus !
Enregistré sur France 2 le 7 janvier 2014 après 20h10,
Lors d’une édition spéciale Charlie HebdoCliquer sur l’image pour voir la vidéo.
Regardez aussi comment la nana est gênée, dès qu’elle se rend compte qu’elle a fait une connerie en révélant par inadvertance, dans son emportement émotionnel, que le "terroriste" dont elle parle avait les yeux bleus !
Et aussitôt, la caméra s’éloigne ! cesse de zoomer sur son visage, afin que cette gêne ne se voit pas trop.
-
Charlie - La liberté d’expression, c’est pas pour tout le monde !
15 janvier 2015, par anonyme
Pierre Piccinin : Je ne suis pas CHARLIE ! Moi, je suis CLAUDE !!!
Claude, il y a quelques jours, a découvert, dans son fil d’actualité, le petit placard que j’avais posté sur ma page, la veille, très tard ; je l’avais moi-même emprunté à un ami algérien, qui vit à Toulouse :
« Je ne suis pas Charlie ; Je suis la Palestine qui se fait voler… ; Je suis la Syrie qui se fait bombarder… ; Je suis l’Afrique qui meurt de faim et de massacre… »
Claude a imprimé le placard et l’a affiché au tableau noir de sa salle de cours. Au soir de cette journée-là, Claude m’écrit… Dans l’après-midi, une petite troupe aux babines haineuses s’est présentée à sa porte. Des étudiants, plusieurs de ses collègues, quelques parents d’élèves…
-
À PARIS, DIMANCHE, UN CAMP IMPÉRIALISTE A PRIS SA MESURE
15 janvier 2015
Le seul intérêt politique de la manifestation de Paris, le 11 janvier 2015, fut de donner un aperçu des pays du camp européen regroupés autour de la bourgeoisie française. Dénombrez les têtes « démocratiquement » couronnées, présentes dans le cortège, et vous aurez un aperçu des adhérents à l’un des deux camps ennemis et de ses capacités à mobiliser la populace.
-
Charlie - Vont-ils faire un fichier des 61 millions de personnes suspectes ?
15 janvier 2015, par anonyme
Y AVAIT-IL AUTANT DE PARTICIPANTS À LA GRAND-MESSE DE DIMANCHE QU’ON NOUS L’A DIT ?
Vont-ils faire un fichier des 61 millions de personnes qui n’ont pas été à la grand-messe "anti-terroriste" du dimanche 11 janvier 2015 ?
En fait, ce n’est probablement pas seulement 61 millions de suspects qu’ils doivent mettre en fiche, mais quelques millions de plus. En effet, comme quand il s’agit de manifs contestataires, les chiffres officiels de la police divisent systématiquement le nombre de manifestants par 3, 4, voire 5, on peut penser que la « marche "citoyenne"’ » du 11 janvier 2015 ayant été convoquée par le pouvoir, le nombre de participants avait été multiplié par la police par 3, 4, voire 5. Certes, cela fait tout de même infiniment trop de monde, mais moins que ce qu’ils ont prétendu. Évidemment.
Avez-vous d’ailleurs remarqué que, d’habitude, on nous dit au sujet des manifs contestataires : « 400 000 personnes selon les organisateurs, mais seulement 100 000 selon la police » ; mais que, là, on nous a donné un seul chiffre : 4 millions. Cela aurait pourtant été fort rigolo qu’ils nous disent quelque chose comme : « 1 million de personnes selon le pouvoir qui avait organisé la grand-messe, et 4 millions selon la police » !
-
Charlie Hebdo - L’attentat vu par Giulietto Chiesa et par Peter Moore (vidéos 6’03 et 19’49)
15 janvier 2015, par anonymeGiulietto Chiesa ancien député européen devenu journaliste
À la télé talienne le 11 janvier 2015
Cliquer sur l’image pour voir la vidéo.
Cliquer ici pour la vidéo avec Peter Moore et pour les commentaires
-
Palestine - 14 janvier 2015 - Où êtes-vous, les Charlie ?
15 janvier 2015, par anonyme
Ou Vous êtes les Charlie ?
Un soldat israélien qui se prend en photo avec un Enfant Palestinien qu’il vient de torturer, avant de le tuer !
Je compte sur vous pour quelle fasse le tour de Facebook.
-
Les affaires continuent !!!
14 janvier 2015, par anonymeIl y a moins de deux heures, un exemplaire du n° 1178 de Charlie Hebdo a été mis aux enchères sur eBay à 10.000.000,00 EUR… avec frais d’envoi gratuits, tout de même… L"annonce ne précise pas si il sera envoyé simplement par la poste, ou bien si un fourgon blindé sera affrété.
-
Charlie - 14 janvier 2014 - Al-Qaïda revendique l’attentat or al-Qaïda appartient aux services secrets occidentaux (vidéos)
14 janvier 2015, par anonymeAQMI appartient aux services secret français
Cliquer sur l’image pour voir cette vidéo de 2 minutes.
Extrait d’un 19-20 de France 3 en février 2007
AQMI, Al-Qaïda au Maghreb Islamique, c’est le nouveau nom du GSPC, qui était lui-même le nouveau nom du GIA. Il y a des preuves comme quoi ce groupe, originellement localisé en Algérie, est manipulé par les services secrets français. Tout ce que fait AQMI et ses descendances est par conséquent commandité par l’État français !
Ben Laden était un agent de la CIA.
Cliquer ici pour l’autre vidéo, l’article et les commentaires
-
Charlie hebdo - Un policier chargé de l’enquête se suicide !
14 janvier 2015, par anonyme Le commissaire de police Helric Fredou, chargé d’enquêter sur l’attentat à Charlie Hebdo, s’est suicidé dans la nuit de jeudi à son bureau avec son arme de service.
Le commissaire de police Helric Fredou, chargé d’enquêter sur l’attentat à Charlie Hebdo, s’est suicidé dans la nuit de jeudi à son bureau avec son arme de service.Il avait notamment enquêté auprès de la famille de l’une des victimes. Il s’est tué avant même de remettre son rapport.
-
Charlie Hebdo - Même à la BBC, la fameuse télé anglaise, ils parlent d’attentat sous faux drapeau (vidéo 1’18)
14 janvier 2015, par anonymeBBC NEWS : « Paris shooting is a lalse flag »
Regardez la croix qui marque l’emplacement de la bagnole !
11 janvier 2015
-
Charlie - Assaut du 8 janvier 2015 à l’hyper cacher porte de Vincennes - du scandale à l’étrange - La vérité est ailleurs ! (vidéos 3’45)
14 janvier 2015, par anonymeLe preneur d’otage Amedy Coulibaly abattu les mains menottées ?
Cliquer sur l’image pour voir la vidéo.
S’ils ont tué le preneur d’otage, c’est pour le faire taire ; en effet, ils n’avaient nul besoin de le tuer, puisqu’il avait déjà les mains menottées ! C’est une preuve de plus qu’ils ont quelque chose à cacher : ils avaient peur que Coulibaly parle ! Que peut-on bien vouloir nous cacher, sinon que ce sont les services secrets qui ont organisé tout ça ?!
Cliquer ici pour l’article, une autre vidéo très étrange, et les commentaires
-
EIN VOLK, EIN REICH, EIN FÜHRER ! tel est l’état de la France au 11 janvier 2015 !
13 janvier 2015, par anonymeLa grand-messe du dimanche
Extraits de Propaganda 3
Cliquer sur l’image pour voir la vidéo.
L’Union Sacrée, l’unité, c’est la collaboration de classe tant souhaitée par Hitler, auteur du fameux slogan « Ein volk, ein reich, ein führer ! », qui signifie « Un seul peuple, un seul royaume, un seul guide ! », et qui est l’exact contraire de la lutte des classes.
La lutte de classe se relèvera de ses cendres ; car il reste des braises sous la cendre, comme disaient les résistants en 40, et qu’une étincelle peut mettre le feu à la prairie, comme disait Mao Tse Toung !
-
Charlie Hebdo fait de la propagande pour le pouvoir
12 janvier 2015
Le slogan choisi par le pouvoir a parcouru la France entière pendant la grand-messe qu’il avait convoquée dimanche dernier : « Vive Charlie ! Vive les flics ! vive les juifs ! ». Ils ont intoxiqué même les gosses. Charlie Hebdo est un organe du pouvoir depuis le coup d’État de Philippe Val. Que ceux qui ont réussi à l’ignorer jusqu’ici ouvrent enfin les yeux !
Rassurons-nous un peu tout de même : puisque la police divise par 3, 4 ou 5 le nombre de participants à une manif contestataire ; alors, forcément, à l’inverse, ils ont multiplié par 3, 4 ou 5 le nombre de participants à la "marche républicaine" organisée par, et donc pour, le pouvoir.
-
Charlie Hebdo sait comment reconnaître un socialiste
12 janvier 2015, par anonyme -
Le gaz de schiste et la perception touarègue d’une semi-colonie au sud.
12 janvier 2015, par anonymeMohamed Bouhamidi. le 11-01-2015 Le message le plus clair et le moins entendu des manifestations animées au sud de l’Algérie contre le gaz de schiste se résume à une formule : « Stop ! Ici, c’est notre territoire. Vous ne pouvez pas tout faire sur notre terre. ». L’opposition et la presse de différentes obédiences extranationales n’ont pas mieux saisi l’avertissement, se contentant de saisir l’aubaine juste pour frapper le pouvoir de l’accusation de rupture avec les citoyens en général ou, pire, (...) -
En 2012, Guy Bedos n’était pas du tout Charlie (vidéo 49’’)
12 janvier 2015, par anonyme« J’ai pas de leçon d’insolence à recevoir de gens qui se sont couchés devant Philippe Val, qui s’est couché devant Sarkozy pour devenir directeur de France-Inter ! »
Cliquer sur l’image pour voir la vidéo.
-
La fausse bonne conscience de l’Occident face au terrorisme
11 janvier 2015C’est en 1993 que Samuel P. Huntington publia son désormais célèbre Choc des civilisations. Pour l’auteur, la défaite de l’Union soviétique avait mis fin à toutes les querelles idéologiques, mais pas à l’histoire. La culture - et non la politique ou l’économie - allait dominer le monde. Il en dénombrait huit : occidentale, confucéenne, japonaise, islamique, hindoue, slave orthodoxe, latino-américaine et, peut-être, africaine (il n’était probablement pas certain que l’Afrique soit vraiment civilisée !). (...) -
AVEC PHILIPPE VAL CHARLIE HEBDO A TRAHI PROFESSEUR CHORON ET HARA KIRI !
11 janvier 2015, par anonymeJe ne suis pas Charlie par Loch Lomond :
Nous sommes tous Charlie" proclame Libération,
et bien non pas moi,
Je n’ai pas fait campagne en faveur du traité de Maastricht, je ne suis pas Charlie,
Je n’ai jamais amalgamé le PCF et le FN, je ne suis pas Charlie,
Je n’ai pas soutenu les bombardements de l’OTAN sur la Yougoslavie, je ne suis pas Charlie,
Je n’ai pas fait campagne pour le OUI au référendum sur la constitution européenne en 2005, je ne suis pas Charlie,
Je n’ai pas cherché à enfoncer Denis Robert et défendu clearstream, je ne pas Charlie,
Je ne prend pas partie, systématiquement pour Israël contre les palestiniens, je ne suis pas Charlie,Etc.
-
LES CHARLIE SONT DES CHARLOTS ET DES CHARLATANS
11 janvier 2015, par anonymeTous les Charlie sont des manipulés ou des manipulateurs !
Hé ! les Charlie ! vous allez manifester derrière Hollande, Sarkozy, Netanyahu, Merkel, etc ?
Ouvrez donc vos yeux !!
-
Espoir avec la découverte d’un nouvel antibiotique, la teixobactine
11 janvier 2015, par anonyme La découverte de nouveaux antibiotiques s’est progressivement tarie. Ce phénomène s’explique par le désintérêt croissant des industriels pour des médicaments utilisés le plus souvent pour de brèves périodes et dont la durée de vie sur le marché est écourtée par le développement des résistances.
La découverte de nouveaux antibiotiques s’est progressivement tarie. Ce phénomène s’explique par le désintérêt croissant des industriels pour des médicaments utilisés le plus souvent pour de brèves périodes et dont la durée de vie sur le marché est écourtée par le développement des résistances. -
Vigipirate - 11 janvier 2015 - Coup d’État en France - 1.350 militaires mobilisés en région parisienne
11 janvier 2015, par anonymeCoïncidence, ce 11 janvier sera également le jour du 2e anniversaire du lancement de l’opération Serval dont l’objectif était de chasser les groupes jihadistes (al-Qaïda au Maghreb islamique, Ansar Dine et le Mouvement pour l’unicité et le jihad en Afrique de l’ouest) du Nord-Mali…
-
Démonstration de Solidarité
11 janvier 2015La France, comme bien d’autres pays avant elle, a connu récemment des attaques (terroristes) sur son territoire. À la suite de ces attaques, un mouvement de solidarité est né et s’est propagé, répandu au sein du peuple français aussi vite que les attaques qui en sont à l’origine.
Réponse de do : Ce texte part sans aucun doute d’une bonne intention mais est empreint d’une grande naïveté. Et pour commencer, quand il y a un "attentat terroriste", il faut toujours au minimum se poser la question de savoir si ce ne serait pas les services secrets du pays où il a eu lieu qui auraient commandité, voire organisé et exécuté eux-mêmes cet attentat !
Et puis, Franchement, solidarité… mais, solidarité avec QUI ?
Avec Hollande, Sarkozy, Netanyahou, Merkel, etc. ?!
Pas question !
Quand toutes ces ordures sont dans la même manif, dans la même solidarité qui n’est en fait qu’Union Sacrée comme en 14-18, qui n’est que collaboration de classe, alors moi j’y vais pas !
VIVE LA LUTTE DE CLASSE !
-
Pour empêcher le Ciel de tomber
10 janvier 2015Suite au massacre, particulièrement révoltant, de ce que l’on nous présente comme la "fine fleur" de l’humour français, la meilleure forme de résistance serait donc, selon un réflexe largement conditionné, de continuer leur œuvre de rigolade tous azimuts…
Cela nous rappelle immanquablement ce refrain d’Henri Salvador réaffirmant que nos ancêtres les gaulois n’avaient qu’une seule crainte :
Que le ciel leur tombe sur la tête !
Et leur antidote :
"Faut rigoler, faut rigoler

Avant qu’le ciel nous tomb’ sur la tête
Faut rigoler, faut rigoler
Pour empêcher le ciel de tomber"
Mais les "malédictions divines", à l’évidence, loin de tomber du "ciel", ne sont que celles de ses affidés, et il est tout à fait possible de les conjurer, à condition de savoir de quel "ciel" elles tombent !
-
Ils ont fait taire Khaled Kelkal, ils ont fait taire Mohammed Merah, ils feront taire les frères Kouachi !
9 janvier 2015, par do
PAS DEUX SANS QUATRE !
Chiche laissez en vie les frères Kouachi afin de pouvoir les interroger !
(Par une police indépendante des services secrets).
-
Charlie Hebdo - La stratégie du choc avouée par Hollande (vidéo 11’’)
9 janvier 2015, par doLes révélations involontaires de Hollande
Cliquer sur l’image pour voir la vidéo.
Hollande doute qu’il s’agisse d’un attentat, il doute que cela ait été commis par des terroristes, et il doute qu’il n’y ait pas de doute… Mais il ne doute pas que la France soit en état de choc, comme aurait dit Naomi Klein !
Si Hollande éprouve le besoin de bien préciser qu’il s’agit d’un attentat, c’est parce que ce n’en est pas un : c’est un coup monté !
Si Hollande éprouve le besoin de bien préciser que ce sont des terroristes qui ont fait le coup, c’est que ce sont en fait les services secrets qui ont tout manigancé.
Si Hollande éprouve le besoin de bien préciser qu’il n’y a aucun doute sur la thèse de l’« attentat » qui est … « terroriste », c’est qu’il vient de placer deux gros mensonges en deux mots !
-
Thierry Meyssan pense à tord que les Amerloques ont probablement commandité l’attentat contre Charlie Hebdo
9 janvier 2015, par anonymeThierry Meyssan : Nous devons nous souvenir que, depuis le démembrement de la Yougoslavie, l’état-major états-unien a expérimenté et mis en pratique dans de très nombreux pays sa stratégie des « combats de chiens ». Elle consiste à tuer des membres de la communauté majoritaire, puis des membres des minorités en renvoyant les responsabilités dos-à-dos jusqu’à ce que chacun soit convaincu d’être en danger de mort. C’est de cette manière que Washington a provoqué la guerre civile aussi bien en Yougoslavie que dernièrement en Ukraine.
Réponse de do :
Je ne dis pas que la CIA ne soit pas capable d’un coup pareil, mais quel serait le mobile des Amerloques ?
Pour la Yougoslavie, qui était "communiste", et où devaient passer des tuyaux à hydrocarbures ("pipe-line", en anglais), on comprend. Milosevic leur déplaisait fortement. Pour l’Ukraine, qui se donnait à la Russie du très désobéissant Poutine plutôt qu’à l’Occident, on comprend aussi. Mais, pour la France, qui s’est tellement livrée à l’impérialisme américano-sioniste qu’on peut considérer qu’elle est une colonie, même pas de l’Amérique, mais carrément d’Israël, les USA n’ont vraiment aucun intérêt à renverser le régime qui dirige la France !
Par ailleurs, si Thierry Meyssan voit bien que la méthode utilisée par les terroristes de Charlie Hebdo ne correspond pas du tout à celle des mercenaires islamistes de l’empire, pourquoi ne voit-il pas la différence entre ce qui vient de se passer en France et ce qui s’est passé en Ukraine pour provoquer la guerre civile ? En Ukraine, chacun des deux camps a effectivement cru que l’autre lui tirait dessus. Et les tireurs embusqués ne sont à aucun moment entrés dans un bâtiment quelconque au risque de se faire pincer. Et d’ailleurs, ils ne se sont justement pas fait pincer, sinon, ça n’aurait pas marché.
Meyssan se trompe. Ce ne sont pas les services secrets américains qui ont organisé l’attentat terroriste à Charlie Hebdo, mais bel et bien les services secrets français ; permettant ainsi à Hollande d’appeler à l’Union Sacrée derrière lui, de faire remonter sa côte de popularité en jouant au grand chef antiterroriste, et de justifier le coup d’État nommé Vigipirate !
Cliquer ici pour l’article de Meyssan et pour les commentaires
-
Lettre ouverte d’un citoyen français
9 janvier 2015, par anonymeRapide réaction sur l’état de notre pays à la suite de cet attentat
-
JE NE SUIS PAS CHARLIE !
8 janvier 2015, par doLES CHARLIE SONT DES CHARLOTS ET DES CHARLATANS !
Lao Tseu : « Tout le monde tient le beau pour le beau, c’est en cela que réside sa laideur. »
— Tu n’es pas Charlie, do ?
— Non, je ne suis pas Charlie !
— Mais, pourquoi n’es-tu pas Charlie ? aujourd’hui, tout le monde est Charlie !
— Je ne suis pas Charlie, justement parce que tout le monde est Charlie. Ëtre Charlie, aujourd’hui, c’est un mouvement créé par le pouvoir. Être Charlie, c’est dire à l’État et à tous : « Oui, je tombe dans tous les pièges et j’en suis fier ! » Et c’est rajouter : « Faites comme moi ! ». Alors, je ne suis pas Charlie !Franchement, vaudra mieux s’abonner à Siné Mensuel qu’à Charlie Hebdo !
-
Non au terrorisme. À bas le terrorisme d’État !
8 janvier 2015 Ouvriers du monde entier, n’avez-vous jamais entendu ce refrain par le passé ? La guerre mettant aux prises la pseudo démocratie bourgeoise contre la barbarie a été déclarée par ces politiciens incapables de réguler l’économie, mais tout à fait capables de nous mener à la guerre totale : « il faut un combat national contre l’islamisme » a repris un éminent journaliste bourgeois (Serge Moati).
Ouvriers du monde entier, n’avez-vous jamais entendu ce refrain par le passé ? La guerre mettant aux prises la pseudo démocratie bourgeoise contre la barbarie a été déclarée par ces politiciens incapables de réguler l’économie, mais tout à fait capables de nous mener à la guerre totale : « il faut un combat national contre l’islamisme » a repris un éminent journaliste bourgeois (Serge Moati). -
Selon les Iraniens, QUI a tué les caricaturistes de Charlie Hebdo ?
8 janvier 2015, par anonymeLe spectacle du terrorisme est au plus haut
Parce qu’Hollande est au plus basNote de do : C’est vrai ça, comme le font remarquer les Iraniens, que selon la propagande officielle française, ce sont des terroristes islamistes revenant de là-bas loin, avec un sacré entraînement guerrier, qui ont commis le crime terroriste contre Charlie Hebdo. Mais… QUI a financé et commandité ces terroristes islamistes pour leur faire combattre Kadhafi en Libye, puis Bachar el-Assad en Syrie, sinon l’impérialisme américano-franco-sioniste ? À QUI obéissent donc ces mercenaires islamistes recrutés dans le monde entier, et notamment en France, sinon en particulier à l’impérialisme français, à l’État français ?!
Par ailleurs, il est clair que le mode d’action employé par les assassins de Charlie Hebdo n’a rien à voir avec celui couramment utilisé par les terroristes islamistes avec attentats-suicide, etc. La façon de faire des "terroristes" à Charlie Hebdo ressemble en effet bien plus à celle des services secrets.
 Il est bon de remarquer aussi que l’attentat terroriste à Charlie Hebdo va effectivement, comme l’ont dit les médias du pouvoir créer un fossé, une division, et peut-être un clash des civilisations entre les musulmans d’un côté et les Occidentaux de l’autre. Mais, contrairement à ce que les mêmes médias propagandistes du pouvoir ont osé prétendre, ce clash des civilisations n’est pas du tout une volonté des musulmans, c’est bien au contraire une marotte des très sionistes néo-conservateurs américains, en particulier de Samuel Huntington, célèbre auteur en 1996 de "The Clash of Civilizations and the Remaking of World Order". Il se trouve que depuis Sarkozy, la France s’est mise au service de l’impérialisme américano-sioniste.
Il est bon de remarquer aussi que l’attentat terroriste à Charlie Hebdo va effectivement, comme l’ont dit les médias du pouvoir créer un fossé, une division, et peut-être un clash des civilisations entre les musulmans d’un côté et les Occidentaux de l’autre. Mais, contrairement à ce que les mêmes médias propagandistes du pouvoir ont osé prétendre, ce clash des civilisations n’est pas du tout une volonté des musulmans, c’est bien au contraire une marotte des très sionistes néo-conservateurs américains, en particulier de Samuel Huntington, célèbre auteur en 1996 de "The Clash of Civilizations and the Remaking of World Order". Il se trouve que depuis Sarkozy, la France s’est mise au service de l’impérialisme américano-sioniste. -
Le Miracle de charlie hebdo - 7 janvier 2014 - Les flics connaissent déjà les noms des coupables !
8 janvier 2015, par anonymeAvant même d’avoir eu le temps de mener une quelconque enquête un tant soit peu sérieuse, les flics connaissent déjà les coupables : deux frères d’une trentaine d’années et un individu plus jeune. Conclusion : ils se foutent vraiment de notre gueule !
-
Hollande appelle à l’Union Sacrée derrière lui. Étonnant, non ? SANS MOI !
7 janvier 2015, par doLa France entière doit se réunir derrière Hollande "pour gagner". Contre quoi ? contre qui ? mystère ! La France force de paix, a-t-il dit, comme si nous n’étions en guerre nulle part alors qu’on fait la guerre partout, en Libye, en Syrie, au Mali, en Ukraine, etc. Et on fait la guerre même chez nous !
Rassemblez-vous toutes et tous derrière Hollande, puisqu’il vous le demande ! ne contestez pas la loi Macron, ne faites pas grève, acceptez sans rechigner toutes les saloperies faites par le gouvernement Hollande ! C’est ça le sens du discours d’Hollande. Rassemblez-vous !
SANS MOI !
Quant à Vigipirate, ce n’est rien d’autre qu’un coup d’État ! Des flics et des militaires vont protéger les lieux publics contre toute tentative d’occupation par des salariés, des chômeurs, des paysans, des artistes ou des étudiants en colère ! qui se feront tous traiter de "terroristes" !
-
La liberté d’expression n’est pas morte.
7 janvier 2015, par anonymeLes moments de crise ont tendance à faire tenir des propos extrêmes, et à mythifier les victimes. Ce qui m’a conduit à tenter de faire preuve de mesure. Si je suis extrêmement heureux que l’amalgame entre l’Islam et le terrorisme n’ait, à ma connaissance, fait par personne, quelque chose me chagrine. Penser que la liberté d’expression permet de dire absolument tout, c’est renier un de nos principes de l’après-Seconde Guerre mondiale : les discours de haine sont interdits. Si effectivement, je suis un (...) -
Loi Macron - Le secrétaire général de la CGT, Thierry Lepaon, démissionne
7 janvier 2015, par anonyme Le secrétaire général de la CGT, Thierry Lepaon, a démissionné de ses fonctions avec tous les membres du bureau confédéral du syndicat, dans la foulée des affaires qui ont éclaté ces derniers mois, a-t-on appris mercredi de source interne.
Le secrétaire général de la CGT, Thierry Lepaon, a démissionné de ses fonctions avec tous les membres du bureau confédéral du syndicat, dans la foulée des affaires qui ont éclaté ces derniers mois, a-t-on appris mercredi de source interne.Note de do du 7 janvier 2015 :
Entre l’attentat terroriste à Charlie Hebdo ce matin, et cet après-midi la démission de Thierry Lepaon de la direction de la CGT, le pouvoir est à peu près sûr de pouvoir faire passer sa loi Macron.
En effet, le spectacle de terrorisme va servir d’enclume et la CGT de marteau. Avec un secrétaire général honni de sa base, la CGT était incapable d’empêcher des grèves sérieuses contre la régression Macron. Avec un nouveau chef tout neuf et tout beau, en qui tout le monde aura confiance pendant quelques mois, la CGT pourra accomplir sans défaillir sa mission qui consiste à empêcher ou à réduire et détourner les grèves. En plus, avec l’ambiance terroriste, qui fait peur et justifie un État policier, et paralyse les gens, ce travail de la CGT sera facilité.
-
Appel au secours de Siné Mensuel avant qu’il soit trop tard !
7 janvier 2015, par anonyme
Si rien ne se passe, ce numéro, le trente-sixième, sera l’avant-dernier.
Seul l’aide du net peut sauver ce mensuel, il faut le faire savoir, siné gène tout le monde, il est boycotté par les médias, dans les revues de presses sur la télé ou la radio, on parle du canard enchainé, de Charlie hebdo, jamais de Siné.Mensuel…chercher l’erreur ! A l’époque de Siné Hebdo, celui qui en parlait sur france inter s’est fait viré… et Siné Hebdo s’est arrêté
Pour aider Siné mensuel, vous pouvez utiliser ces emails :
presse@sinemensuel.com
abonnement@sinemensuel.com
Et ce numéro de téléphone : 01 43 26 01 11
Mais surtout vous pouvez l’acheter, mieux, vous abonner. ou abonner vos ami-e-s. C’est un superbe cadeau de Noël, mais faites-le immédiatement, comme un Noël en avance, sinon cela risque d’être trop tard !
-
faut divers a sangmelima
6 janvier 2015, par anonymearnaque du régisseur du marche de sangmelima le nomme elomo lopes
-
La Libye et l’entêtement socialiste à poursuivre les crimes de Sarkozy.
5 janvier 2015, par anonymeNous avons beau être des bicots-nègres, la ficelle socialiste est plus grosse que la Rolex de Sarkozy : il s’agit de recréer derrière un leadership français, « La coloniale », les fameux tirailleurs africains qui iront au casse-pipe pour les intérêts coloniaux de la France sur fond d’échec généralisé de la Francophonie et de la Françafrique à préserver l’ancien empire colonial de l’avancée chinoise.
-
À Boston, c’est encore l’école française qui a frappé !
5 janvier 2015, par doL’attentat de Boston est évidemment une manipulation. Cette histoire de cocotte-minute remplie d’explosif et de diverses ferrailles rappelle fort l’attentat de Vaillant à l’Assemblée française le 9 décembre 1893 (À Boston, c’est encore L’école française qui a frappé ! dirait peut-être Marie-Monique Robin). Et le policier qui avait manipulé Auguste Vaillant écrivit plus tard lui-même un livre où il expliquait la manipulation : « La marmite pleine de ferrailles qui a explosée dans l’enceinte de l’Assemblée ne pouvait pas faire beaucoup de morts, mais allait beaucoup impressionner les députés et les inciter à voter diverses lois liberticides », écrivait-il.
-
LE SPECTACLE DE BOSTON
5 janvier 2015, par anarchie« Les bombes-fusées qui tombaient chaque jour sur Londres étaient probablement lancées par le gouvernement de l’Océania lui-même, "juste pour maintenir les gens dans la peur" » 1984 d’Orwell. De l’Attentat de la gare de Bologne à celui du Marathon de Boston en passant par tous les 11 septembre petits, grands ou moyens, le terrorisme c’est toujours et partout le spectacle d’imposture étatique de la crise mondiale du chaos de la marchandise ! Note de do : ne loupez pas cet article qui est une analyse assez complète et qui est jusqu’à présent le meilleur texte sur Boston.
-
Attentat de Boston aux USA - 22 avril 2013 - vidéos américaines dénonçant une manipulation
5 janvier 2015Le Lieutenant Colonel Potter dénonce la mise en scène de Boston
Cliquer sur l’image pour voir la vidéo de 9’05.
Le Lieutenant Colonel Potter a servi dans divers postes de police militaire et du renseignement militaire dans le monde entier durant 28 ans, et affirme qu’il y a en ce moment aux USA une guerre entre diverses fractions du pouvoir et que cela aboutira à l’établissement d’un État policier.
-
Réfugiés palestiniens. L’inconditionnel espoir de retour
5 janvier 2015Les camps de réfugiés palestiniens au Liban se voulaient à l’origine temporaires, comme tous les camps de réfugiés. Les Palestiniens qui fuyaient la violence faisant suite à la création de l’État d’Israël espéraient naturellement retourner un jour sur la terre, pas si lointaine, qu’ils avaient quittée. Aujourd’hui, quelque 450.000 réfugiés sont officiellement enregistrés auprès de l’Office de secours et de travaux pour les réfugiés de Palestine au Proche-Orient (UNRWA - United Nation Relief and Works Agency (...) -
Syrie - Irak - 4 janvier 2015 - Les coopérations, à plusieurs niveaux, entre Daesh et les Etats-Unis
4 janvier 2015, par anonyme« Des avions, à l’identité inconnue, ont largué une grande quantité d’armes et de munitions, pour les terroristes daeshistes, dans la localité d’Al-Dour, dans le Sud-Est de Tikrit », a annoncé Jassem al-Jabara, le Président du comité de la sécurité du Conseil du gouvernorat de Salaheddine.
Auparavant, Mofid al-Baldavi, le gouverneur de la ville de Balad, avait annoncé que les avions de combat de la coalition internationale de la lutte contre Daesh avaient largué des cargaisons d’armes et de marchandises, pour les terroristes, dans le Sud de la province de Salaheddine, et que des centaines d’habitants de cette ville en avaient été témoins.
« L’aéroport de la ville occupée de Mossoul est, chaque jour, témoin du décollage et de l’atterrissage d’avions, à l’identité inconnue, et du transfert de cargaisons d’armes et de munitions, qui sortent de ces avions », ont écrit les médias locaux irakiens, citant Jamila al-Obeïdi, le représentant de la ville de Mossoul, au Parlement irakien.
-
Cécile Duflot part en guerre contre la loi Macron
4 janvier 2015, par anonyme Faire échec au projet de loi sur la croissance et l’activité est un devoir, estime Cécile Duflot, qui voit dans le texte porté par le ministre de l’Economie, Emmanuel Macron, un "grand bond en arrière" en matière d’environnement et un "renoncement social".
Faire échec au projet de loi sur la croissance et l’activité est un devoir, estime Cécile Duflot, qui voit dans le texte porté par le ministre de l’Economie, Emmanuel Macron, un "grand bond en arrière" en matière d’environnement et un "renoncement social". -
tigre
4 janvier 2015, par anonymeJ’ai été frappé par la similitude avec le film d’Akira Kurosawa : Dersou Ouzala, mêmes lieux, mêmes gens, même humilité, même respect pour amba…
-
LA POLITIQUE MILITAIRE DES ÉTATS-UNIS ET DE L’OTAN (LA GUERRE DES OLÉODUCS)
2 janvier 2015 Selon la théorie marxiste, la guerre est la poursuite des activités économiques, politiques et diplomatiques par des moyens drastiques et violents. La guerre civile est la continuation de la politique entre les classes sociales au sein d’un même État. Dans une société de classes, la guerre manifeste la violence réactionnaire de l’ancien régime de classe qui s’accroche au pouvoir. Selon la théorie marxiste, la guerre de conquête est la poursuite des activités économiques, politiques et diplomatiques par des moyens drastiques et violents entre États concurrents.
Selon la théorie marxiste, la guerre est la poursuite des activités économiques, politiques et diplomatiques par des moyens drastiques et violents. La guerre civile est la continuation de la politique entre les classes sociales au sein d’un même État. Dans une société de classes, la guerre manifeste la violence réactionnaire de l’ancien régime de classe qui s’accroche au pouvoir. Selon la théorie marxiste, la guerre de conquête est la poursuite des activités économiques, politiques et diplomatiques par des moyens drastiques et violents entre États concurrents. -
ÉDITEURS ? DISENT-ILS ! Par Guillaume Basquin
2 janvier 2015, par anonymej’ai reçu par retour de courrier avec la mention « Pli refusé par le destinataire » un mien manuscrit déposé par mes soins dans la boîte aux lettres des ex-éditions Galilée. Il n’a pas été ouvert et a été retourné.
Je qualifie Galilée d’ex-éditeur car ce genre de pratique le disqualifie totalement à mes yeux et ne mérite que le plus profond mépris ; c’est qu’on sait depuis Crime et Châtiment de Dostoïevski que le vrai crime, c’est l’aveu du crime. Or la maison Galilée, ce faisant, avoue (flagrant délit) qu’elle ne se donne même pas la peine d’essayer de lire les manuscrits reçus.
-
"Z" comme Zemmour, l’éradicateur
2 janvier 2015, par anonyme Que les thuriféraires de la haine se rassurent, ils prennent leur désirs pour une réalité, fini l’époque de la manipulation aisée, les peuples ne sont plus dupes, bien qu’abrutis par la modernisation ; Celle, ou on prenait les enfants du bon Dieu pour des canards sauvages, juste bons à viser, à tirer et à plumer. Ceux qui, par le vomis de leur fiel, pensent geler le cycle naturel de la vie, se détrompent, parce qu’il en fut toujours ainsi, depuis la nuit des temps, le monde du vivant est une éternelle transhumance.
Que les thuriféraires de la haine se rassurent, ils prennent leur désirs pour une réalité, fini l’époque de la manipulation aisée, les peuples ne sont plus dupes, bien qu’abrutis par la modernisation ; Celle, ou on prenait les enfants du bon Dieu pour des canards sauvages, juste bons à viser, à tirer et à plumer. Ceux qui, par le vomis de leur fiel, pensent geler le cycle naturel de la vie, se détrompent, parce qu’il en fut toujours ainsi, depuis la nuit des temps, le monde du vivant est une éternelle transhumance.Voilà Éric Zemmour, le sauveur de la France, ce paléo berbère de deuxième génération, issu d’un père juif algérien, trahi par son nom « Zemmour veut dire olive en berbère », ce cerbère des médias ‘’libres’’, bien libre quand il s’agit d’encenser une communauté au dépend d’une autre, que l’on dénigre à tout va, en usant même de propos racistes, sans nullement être inquiété.
-
POUR EN FINIR AVEC PIKETTY ET SES HÉRÉSIES
2 janvier 2015Défi redoutable que de faire à la fois la critique de l’économiste et la critique de ses critiques. Nous faisons face ici à un économiste défenseur d’un capitalisme bridé et réformé, lui-même critiqué par des parangons d’un capitalisme débridé

-
Les liens entre les services secrets et la MAFIA ou la pègre sont dévoilés par la guerre de 39-45 (vidéo 66’39)
30 décembre 2014, par anonymeMémé Guérini, Lucky Luciano et Antoine guérini,
Mafieux, mais patriotes !Enregistré sur France 3 le 8 décembre 2014 vers 22h40
De 1935 à 1945, certaines branches de la MAFIA choisirent le bon camp. On leur en fut reconnaissant après guerre…
-
Drogue - Liens entre l’héroïne de la French connection, De Gaulle, le SAC et la MAFIA (Vidéos 3’43 ; 6’22 ; 51’44 et 97’23)
30 décembre 2014, par anonymeFrench connection - De Gaulle - SAC - MAFIA
Extrait (3’43) de la vidéo Canal+ de 2007 intitulée :
« French Connection, les rois de la Came »
Le SAC est une ancienne police parallèle fondée par le très célèbre gaulliste Charles Pasqua, dont on peut dire qu’à l’époque il possédait trois services secrets : celui de l’État, et le SAC, et son clan corse. Il se trouve que parmi les chefs de la French connection, la pègre corse a joué un rôle essentiel.
On peut penser que c’est pour que la CIA remplace les services secrets français à la tête du trafic d’héroïne, qu’il a fallu faire tomber la French connection.
Cliquer ici pour l’article, les autres vidéos et les commentaires
-
Algérie : le dangereux refus de « la paix sociale »
30 décembre 2014, par anonymePour les algériens qui ont de la mémoire, la chute du prix du pétrole réveille le souvenir du processus qui a mené à la grande fracture d’octobre 1988 puis à la lutte sanglante qui en a résulté et qui devait démembrer l’Algérie. Nous retrouvons des similitudes frappantes avec la conduite générale de l’Etat et des acteurs politiques d’aujourd’hui. Les années 80 ont vu une partie importante des revenus pétroliers détournée de leurs destinations d’investissement productif (1) vers l’importation de produits (...) -
États-Unis. Le drame des enfants sans domicile fixe
29 décembre 2014
Aux États-Unis, un enfant sur trente est sans-abri. Ce sont les données qui ressortent du récent rapport publié mi-novembre par le National Center of Family Homelessness (centre national de la famille sans-abri). On apprendra en le lisant que la pauvreté y a fait un bond de 8 % entre 2012 et 2013 et que plus de 2,5 millions d’enfants sont aujourd’hui sans domicile fixe.
-
La bourse - Évolution du CAC40 entre 1964 et 2012
29 décembre 2014, par anonyme
En 1964, il y avait assez d’argent pour de vraies retraites, une vraie sécu, etc. mais maintenant, il n’y en a plus assez, et il faut tout supprimer. Juste un regard sur le graphique ci-dessus, venu de Wikipedia, suffit à démentir les allégations du pouvoir esclavagiste qui nous dirige.
-
Comment conclure une thérapie ? Des psys apportent leurs réponses
27 décembre 2014, par anonyme
Art de la fin : L’adieu au divan peut être aussi difficile qu’une séparation amoureuse, mais il marque aussi parfois une libération, voire une nouvelle naissance. Psychiatres et psychanalystes racontent cet envol.
-
Deux conceptions de l’antiracisme : le paternalisme ou la révolte ?
27 décembre 2014, par anonymeLA LIBERTÉ NE S’OCTROIE PAS ELLE SE PREND !
 « L’Afrique est : couverte de jungle ; un grand safari ; tombe en morceaux ; un continent où la famine sévit ; pleine de la guerre ; montée du sida, déchirée par l’apartheid, bizarre, brutale, sauvage, primitive, en arrière, tribale, sous-développée, et noire »
« L’Afrique est : couverte de jungle ; un grand safari ; tombe en morceaux ; un continent où la famine sévit ; pleine de la guerre ; montée du sida, déchirée par l’apartheid, bizarre, brutale, sauvage, primitive, en arrière, tribale, sous-développée, et noire » -
Palestine - 26 décembre 2014 - La trahison suprême de l’autorité "palestinienne" à l’ONU
26 décembre 2014, par anonymeJihad islamique (et pas islamiste !) palestinien : « Ce qui est dénommé "résolution palestinienne" présentée au conseil de sécurité, avec une couverture arabe, qu’elle ait été modifiée ou non, est en réalité une offre gratuite de liquidation de la cause palestinienne, le but même pour lequel ont été conçus le projet de règlement et les accords d’Oslo. Ce projet/résolution s’appuie, dans son essence et sa formulation, sur ce qui ne fâche pas les États-Unis et satisfait « Israël » »
-
La crise économique de l’impérialisme d’après la théorie marxiste (3e partie de trois)
26 décembre 2014 La semaine dernière, nous avons publié la seconde partie de cette trilogie présentant l’analyse marxiste de la crise économique systémique de l’impérialisme. Nous avons présenté les concepts de capitalisme et d’impérialisme et examiné quelques équations qui définissent le capitalisme monopoliste d’État d’après la théorie marxiste de l’économie politique. Cette semaine nous examinons les questions de la dette souveraine, du crédit à la consommation et de l’industrie militaire.
La semaine dernière, nous avons publié la seconde partie de cette trilogie présentant l’analyse marxiste de la crise économique systémique de l’impérialisme. Nous avons présenté les concepts de capitalisme et d’impérialisme et examiné quelques équations qui définissent le capitalisme monopoliste d’État d’après la théorie marxiste de l’économie politique. Cette semaine nous examinons les questions de la dette souveraine, du crédit à la consommation et de l’industrie militaire. -
"Les Juifs en Palestine" par le Mahatma Gandhi
25 décembre 2014, par anonyme Gandhi : « J’ai reçu plusieurs lettres dans lesquelles on me demande d’exposer mes vues sur la question arabo-juive en Palestine et la persécution anti-juive en Allemagne… Toute ma sympathie est acquise aux Juifs… La Palestine appartient aux Arabes de la manière dont l’Angleterre appartient aux Anglais. »
Gandhi : « J’ai reçu plusieurs lettres dans lesquelles on me demande d’exposer mes vues sur la question arabo-juive en Palestine et la persécution anti-juive en Allemagne… Toute ma sympathie est acquise aux Juifs… La Palestine appartient aux Arabes de la manière dont l’Angleterre appartient aux Anglais. » -
Les dérives médiatiques de Kamel Daoud
25 décembre 2014, par anonymeUne insensée et ruineuse campagne de promotion Par Abdellali MERDACI* Que l’appel d’un imam déjanté aux tribunaux de la République pour juger et infliger une lourde sentence de mort à un écrivain perçu comme blasphémateur envers l’Islam, religion de la majorité des Algériens, soit un fait inhabituel dans notre histoire littéraire, il ne devrait pas moins inviter à réfléchir à ce qui apparaît comme une violente et insupportable campagne de promotion dans les médias français d’un livre et de son auteur aux (...) -
Cuba et la conscience d’un échec US
23 décembre 2014, par anonymeLa presse mainstream salue un « évènement historique » dans l’accord diplomatique entre Cuba et les USA et emboîte le pas aux propos d’Obama : le blocus a échoué à changer les choses sans l’Île de la Liberté. Comprenez : a échoué à « faire tomber le régime ». Dans ces louanges, orchestrées par simple suivisme, l’injustice fondamentale passe à la trappe : les ambassades vont ouvrir, le blocus reste. Au passage le cynisme atteint de nouveaux sommets. Les élites aux commandes de l’Occident jugent le blocus à (...) -
Lutte de classe et résistance - Histoire de la sécurité sociale (vidéo 8’08)
22 décembre 2014, par anonymeLa France était ruinée quand elle a pu créer la Sécu !
Et on veut nous faire croire aujourd’hui qu’on ne peut pas la maintenir
Cliquer sur l’image pour voir la vidéo.
-
De l’« Euromaïdan » à la guerre civile, terreur et terrorisme en Ukraine (2013-2014)
22 décembre 2014, par anonyme
Le drapeau de l’Europe soutient le drapeau rouge et noir de Bandera, le fameux chef des collabos ukrainiens des nazis pendant la deuxième guerre mondiale
Exposé de Frédéric Saillot au colloque sur la géopolitique du terrorisme organisé par l’Académie de géopolitique de Paris le 11 décembre 2014 à l’Assemblée nationale.
Des commandos venus principalement de l’ouest de l’Ukraine, bien organisés et bien entraînés pendant des années, rétribués et dirigés par les services de l’ambassade américaine à Kiev, ont exercé une pression constante et relancé la mobilisation à chaque fois qu’elle s’essoufflait. J’en veux pour preuve, entre autres, que la SBU, la sécurité ukrainienne, est actuellement dirigée par Valentin Nalivaïtchenko, agent de la CIA comme il le reconnaît lui-même, et proche du chef du Pravy Sektor, Dimitri Yarosh, qui a été son assistant parlementaire.
Le concept de "guerre totale" développé par l’école de guerre américaine, définit la guerre moderne comme étant faite contre les civils pour ruiner le pays et conduire à la démission du gouvernement.
L’est de l’Ukraine est riche en réserves de gaz de schiste, auquel est intéressé le propre fils du vice-président américain Biden, très impliqué dans la conduite de l’ATO, qui a été déclenchée à l’occasion de sa visite à Kiev en avril. Le génocide des populations russophones de l’est de l’Ukraine est donc économiquement motivé.
-
France - 22 décembre 2014 - Avec l’ANI, ils veulent détruire la sécurité sociale et les vraies mutuelles de santé
22 décembre 2014, par anonymeMUTUELLES : le loup dans la bergerie pour la mise à mort de la sécu !
L’accord national interprofessionnel (ANI) rend obligatoire au 1er janvier 2016 l’adhésion des salariés à une complémentaire santé d’entreprise. Malgré les apparences, cette disposition n’est pas une avancée sociale : elle ouvre un énorme marché aux assurances privées au détriment de la protection sociale collective.
La Mutualité pourrait disparaître d’ici quelques années au profit de groupes capitalistes qui bénéficieront du monopole des complémentaires santé.
Notre ministre de la santé, Marisol Touraine, pense que les mutuelles devraient rembourser moins afin que par ricocher les professionnels diminuent leurs tarifs, car d’après elle, « les complémentaires trop généreuses finissent par entretenir des honoraires trop élevés. », et qu’elle faisait « le pari de l’autorégulation ». C’est quand même très original de se dire que quand le patient sera peu remboursé, le médecin baissera gentiment ses tarifs, d’autant que beaucoup de patients sont déjà mal remboursés !
Les entreprises auraient assez d’argent pour financer des contrats de mutuelles d’entreprises mais pas assez pour payer des cotisations de sécurité sociale ! D’autre part, on ne parle jamais assez des caisses d’Assurance Maladie Alsace-Moselle qui remboursent mieux par exemple à 90% une visite chez un généraliste sur le tarif conventionné ? Caisses qui sont bénéficiaires ? Comment ? Pourquoi ?
-
Corée du Nord - 21 décembre 2014 - C’est la CIA qui a piraté Sony ! (Vidéo 5’12)
21 décembre 2014, par doLe piratage de Sony est une provocation américaine
À but de propagande contre la Corée du NordEnregistré au 20 heures de France 2 du 20 décembre 2014
Cliquer sur l’image pour voir la vidéo.
Ne pouvant faire la guerre à la Corée du Nord au sens propre du mot parce que ce pays a la Bombe, les Amerloques utilisent une autre arme, absolue celle-là, et qui leur a permis de vaincre même l’URSS : la propagande !
C’est pour la CIA qu’il est le plus facile de pirater n’importe quel site internet, puisque tout internet passe par quelques superordinateurs tous logés aux USA. La CIA a donc accès à toutes les données, et même si celles-ci sont cryptées, car rien ne prouve que la CIA ne possède pas une ou plusieurs clefs SSL qui lui servent de passe-partout. La CIA possède peut-être tous vos mots de passe.
Par ailleurs, cette propagande contre la Corée du Nord sert aussi à attaquer internet en soi, c’est-à-dire à en justifier le contrôle par le "super-protecteur" américain en qui tout le monde a toute confiance depuis Snowden.
-
DU BRUIT DANS LANDERNEAU...
21 décembre 2014
(Nouvelle édition)
Viré du site "Bellaciao", cet article, initialement publié sur Tribune Marxiste-Léniniste, refait donc une apparition sur VLR !
"Selon l’explication communément admise, cette expression, « faire du bruit dans Landerneau » serait tirée d’une comédie d’Alexandre Duval, Les Héritiers, ou le Naufrage, dont la première représentation eut lieu en 1796, et dans laquelle le héros, miraculeusement sauvé d’un naufrage, s’en revient dans son château, situé non loin de la petite ville de Landerneau, au moment où l’on s’apprête à partager son héritage. En le voyant paraître, son domestique s’écrie : « Oh ! le bon tour ! Je ne dirai rien, mais cela fera du bruit dans Landerneau. »
-
USA en Irak "contre" DAECH - 20 décembre 2014 - après les bombardements bidons, les livraisons de munitions périmées
20 décembre 2014, par anonyme
Ces obus auraient dû arriver aux forces terrestres de l’armée et aux forces de sécurité en guerre contre Daech ; or, le pentagone a d’abord bien retardé leur livraison, puis il nous a floués avec des obus qui ne marchent pas !!
Depuis le début de leurs soit-disantes frappes aériennes contre Daech, les États-Unis n’ont pas cessé de bombarder les positions des forces irakiennes en lieu et place de celles de Daech, de transférer les données confidentielles aux terroristes pour empêcher l’avancée des forces nationales … sans l’aide substantielle de la coalition "anti-Daech", Daech n’aurait jamais pu résister plus d’un mois aux forces volontaires irakiennes.
-
La crise économique de l’impérialisme d’après la théorie marxiste (2e partie de trois)
20 décembre 2014 La semaine dernière, nous avons publié la première partie de ce triptyque présentant l’analyse marxiste de la crise économique de l’impérialisme en déclin. Après avoir présenté les concepts de capitalisme et d’impérialisme voyons maintenant six lois qui définissent les caractéristiques du capitalisme monopoliste d’État d’après la théorie marxiste d’économie politique.
La semaine dernière, nous avons publié la première partie de ce triptyque présentant l’analyse marxiste de la crise économique de l’impérialisme en déclin. Après avoir présenté les concepts de capitalisme et d’impérialisme voyons maintenant six lois qui définissent les caractéristiques du capitalisme monopoliste d’État d’après la théorie marxiste d’économie politique. -
Réconciliation USA-Cuba ? ou propagande pro-américaine, ET guerre contre la Russie ?
20 décembre 2014, par doRéconciliation ? faites-moi pas rire ! le blocus américain contre Cuba n’est toujours pas levé !

En fait il s’agit de propagande de la part des Amerloques car ils sont en ce moment-même déconsidérés dans le monde entier. Alors ils essaient de se faire bien voir en faisant semblant de cesser de mettre le communisme cubain au ban de l’humanité.
Par ailleurs, les Amerloques sont en guerre permanente contre la Russie. Or Cuba est un allié de la Russie. Alors si cette propagande, pourtant si vulgaire, pouvait leur permettre de "diviser pour mieux régner", et séparer cuba de la Russie, ce serait tout bénéfice pour l’impérialisme américano-sioniste.
-
Le « home run » de la diplomatie cubaine. (Viktor DEDAJ du LGS)
20 décembre 2014, par anonyme Voici une casse-tête pour les médias : comment présenter une déculottée en rase-campagne des Etats-Unis comme un « geste symbolique et fort » de son président chouchou ? Facile : omettez le contexte, oubliez l’Histoire, opérez quelques « ruptures narratives », faites semblant d’informer aujourd’hui sur ce que vous avez soigneusement occulté hier, et voilà le travail : le grotesque « Prix Nobel de la Paix » aux mille meurtres par drones vient de marcher sur la lune. Même qu’au prochain Halloween, il ne manquera pas de gracier une dinde. Eh ouais, il est comme ça, le président super-cool des Etats-Unis d’Amérique. Et il faut bien ça pour laisser une empreinte dans l’Histoire qui ne soit pas celle d’une botte militaire.
Voici une casse-tête pour les médias : comment présenter une déculottée en rase-campagne des Etats-Unis comme un « geste symbolique et fort » de son président chouchou ? Facile : omettez le contexte, oubliez l’Histoire, opérez quelques « ruptures narratives », faites semblant d’informer aujourd’hui sur ce que vous avez soigneusement occulté hier, et voilà le travail : le grotesque « Prix Nobel de la Paix » aux mille meurtres par drones vient de marcher sur la lune. Même qu’au prochain Halloween, il ne manquera pas de gracier une dinde. Eh ouais, il est comme ça, le président super-cool des Etats-Unis d’Amérique. Et il faut bien ça pour laisser une empreinte dans l’Histoire qui ne soit pas celle d’une botte militaire. -
CUBA : ils l’ont dans ...l’os ! (Jean ORTIZ du LGS)
20 décembre 2014, par anonyme Devant cette gifle historique, nos médiocrates s’étouffent, ergotent, déforment, manœuvrent, enfument.
Devant cette gifle historique, nos médiocrates s’étouffent, ergotent, déforment, manœuvrent, enfument.Dieu qu’ils ont du mal à le digérer !! Dans la dignité et l’honneur, sans quémander, sans renoncer à ce qu’il est, en toute souveraineté, David a fini par terrasser Goliath.
-
USA - 1931 - Coca Cola dessine le Père Noël pour sa publicité
19 décembre 2014, par anonyme L’hiver étant une période moins propice à la consommation de la célèbre boisson gazeuse, quoi de mieux qu’un symbole mondialement connu et immédiatement reconnu ? La firme Américaine a eu le génie de demander à Haddon SUNDBLOM de dessiner ce vieux bonhomme (dont la renommée grandissait sur le continent américain) en train de boire du Coca Cola pour reprendre des forces pendant la distribution de jouets. Ainsi les enfants seraient incités à en boire durant l’hiver.
L’hiver étant une période moins propice à la consommation de la célèbre boisson gazeuse, quoi de mieux qu’un symbole mondialement connu et immédiatement reconnu ? La firme Américaine a eu le génie de demander à Haddon SUNDBLOM de dessiner ce vieux bonhomme (dont la renommée grandissait sur le continent américain) en train de boire du Coca Cola pour reprendre des forces pendant la distribution de jouets. Ainsi les enfants seraient incités à en boire durant l’hiver. -
Le grave laxisme du recrutement au sein de l’éducation nationale montré du doigt
19 décembre 2014, par anonymeA l’origine, un simple règlement de compte dans la diaspora Djiboutienne, comme il en arrive régulièrement parmi ces groupuscules politiques désorganisés.
-
Pakistan - 17 décembre 2014 - Attentat commandité par le pouvoir contre une centaine d’enfants de soldats
17 décembre 2014, par anonymeHorrible attentat au Pakistan, attribué aux "talibans" par les médias, mais commandité par le pouvoir pour convaincre la population, et surtout les soldats pakistanais, de faire effectivement la guerre contre la résistance anti-américaine. Démonstration ? inutile, c’est l’évidence même !
-
Hollande promet d’augmenter l’âge de la retraite ! (Vidéos 9’’ ; 1’11 ; 11’’)
15 décembre 2014Hollande avoue ne plus être socialiste
Enregistré sur France 2 le 28 mars 2013 après 20h15
Cliquer sur l’image pour voir la vidéo.
Pour justifier l’augmentation de l’âge de la retraite, Hollande a prétendu que l’on vit plus longtemps. Ce qui est un mensonge ! Avec la destruction de la sécurité sociale, la destruction des services publics et la diminution perpétuelle du pouvoir d’achat, les gens se soignent de moins en moins bien, et meurent de plus en plus jeunes depuis trois ou quatre ans !
Mais c’est normal qu’Hollande recherche du fric ; car, non seulement il faut bien qu’il enrichisse les riches avec l’argent des pauvres ; mais, en plus, il lui faut financer les guerres impérialistes. Tiens, à propos de guerres impérialistes, Hollande a justifié la colonisation de la même façon que cela se faisait au dix neuvième siècle : « La France ne colonise pas, elle apporte la civilisation ! » C’est vraiment du Jules Ferry ! Ainsi, nous avons la réponse à la question de savoir pour quelle raison au début de son mandat, Hollande avait rendu hommage à cet odieux personnage !
NE DITES PLUS HOLLANDE, MAIS SARKONAZI II
Cliquer ici pour l’article, les autres vidéos et les commentaires.
-
La crise économique de l’impérialisme d’après la théorie marxiste
15 décembre 2014Quelle est l’étape urgente des activités de la gauche révolutionnaire dans le mouvement ouvrier contemporain ? Ce n’est pas de structurer les ouvriers dans des mouvements de résistance à la crise systémique du capitalisme. Ce n’est pas non plus de les rassembler dans des bataillons de combat pour monter aux barricades insurrectionnelles. Ce n’est pas davantage de les mobiliser pour les luttes grévistes…

-
Ziad Abou Aïn : la presse servile et le ministre palestinien.
15 décembre 2014, par anonymeLe corps de Ziad Abou Aïn n’avait pas refroidi que des titres supposés prestigieux de la presse mainstream annonçaient mercredi 10 décembre la mort d’un haut responsable palestinien sans nom et sans statut renvoyé à une mort anonyme instantanément dépassée par la question logique qui suit immédiatement de savoir à quelle brigade « terroriste » il appartient et s’il est Hamas, Djihad Islamique ou FPLP ? Cet anonymat ouvre toute grande les réponses déjà préparées par un matraquage médiatique incessant : l’armée « la plus morale du monde » a « liquidé » un méchant.
-
La crise économique de l’impérialisme d’après la théorie marxiste
15 décembre 2014 Quelle est l’étape urgente des activités de la gauche révolutionnaire dans le mouvement ouvrier contemporain ? Ce n’est pas de structurer les ouvriers dans des mouvements de résistance à la crise systémique du capitalisme. Ce n’est pas non plus de les rassembler dans des bataillons de combat pour monter aux barricades insurrectionnelles.
Quelle est l’étape urgente des activités de la gauche révolutionnaire dans le mouvement ouvrier contemporain ? Ce n’est pas de structurer les ouvriers dans des mouvements de résistance à la crise systémique du capitalisme. Ce n’est pas non plus de les rassembler dans des bataillons de combat pour monter aux barricades insurrectionnelles. -
France-Allemagne - D’après les sondo-mensonges, 72% des Français seraient des collabos
14 décembre 2014, par doAngela Merkel recueille 72% d’opinions favorables en France, selon un "sondage" paru aujourd’hui dimanche 14 décembre 2014. Il s’agit évidemment d’une propagande du pouvoir pour nous faire accepter une destruction encore plus grandes de nos avantages acquis par la lutte de classe. Au lieu de tomber dans tous les pièges, reprenons la lutte de classe : Tous en grève ! Refaisons mai 68 !
... | 2600 | 2700 | 2800 | 2900 | 3000 | 3100 | 3200 | 3300 | 3400 |...
Derniers commentaires
- 26 avril 2017 – Que le PCF disparaisse est une chose, mais pas s’il doit être remplacé par (...)
- 10 mars 2017 – Respecter la JUSTICE de CLASSE et BAVEUSE (OUTREAU) ? Respecter la PRESSE (...)
- 10 mars 2017 – En politique, la naïveté est condamnable… Il aurait dû voir venir de loin le (...)
- 9 mars 2017 – Bonjour, Le nombre de français de plus de 18 ans est estimé à 52 millions… (...)
- 9 mars 2017 – Voici l’affiche du casseur en très grand : http://mai68.org/spip/IMG/jpg/mai_G.jp
- 9 mars 2017 – Hamon veut un parlement de la zone euro pour en finir avec l’austérité (...)
- 9 mars 2017 – Si on suppose que le RU ne rapporte rien à l’État, alors, donner sans (...)
- 9 mars 2017 – Autrement dit, pour 100 milliards d’Euros par an, on pourrait faire un (...)


